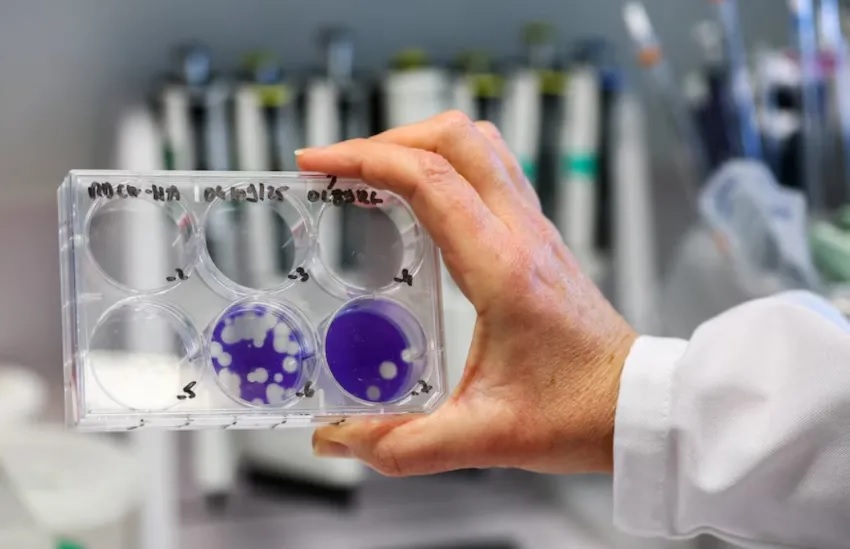

ESTUDIANTES DE ESCUELAS TÉCNICAS REALIZARÁN PASANTÍAS EN EL IPDUV
POLÍTICA: SANTILLI ANTICIPÓ QUE EL GOBIERNO BUSCARÁ REPONER EL CAPÍTULO 11 DEL PRESUPUESTO EN EL SENADO
El ministro del Interior sostuvo que la eliminación de ese apartado puede generar desequilibrios fiscales y afirmó que el oficialismo trabajará para corregirlo en la Cámara Alta. El funcionario reconoció tensiones políticas, pero remarcó que el Presupuesto 2026 representa "un paso muy importante" después de tres años sin ley de gastos.
El ministro del Interior, Diego Santilli, anticipó que el Gobierno nacional buscará reponer en el Senado el capítulo 11 del Presupuesto 2026, impulsado por el presidente Javier Milei y rechazado durante el tratamiento en la Cámara de Diputados. Ese apartado incluía la derogación de las leyes de Emergencia en Discapacidad y de Financiamiento Universitario, y fue uno de los puntos que generó mayor resistencia de la oposición durante la sesión en la que el proyecto obtuvo media sanción.
En declaraciones radiales, Santilli sostuvo que la eliminación de ese capítulo podría generar problemas a futuro. "Ese punto te puede generar un desequilibrio hacia adelante, que para mí hay que corregirlo en el Senado", afirmó. En ese marco, el funcionario hizo referencia al rol de los gobernadores en el debate parlamentario y señaló que no todos lograron alinear a sus legisladores con la postura del Ejecutivo. "Hubo gobernadores que no pudieron convencer de ese cambio cultural a muchos o a algunos de sus diputados", expresó.
El ministro remarcó que, más allá de las diferencias, el oficialismo valora el respaldo general que tuvo la iniciativa. "Lo que se logró es un paso muy importante, venimos de tres años sin presupuesto", aseguró. Según explicó, el eje de la discusión está puesto en evitar asignaciones que superen los límites establecidos y puedan comprometer el equilibrio fiscal. "Es innegociable tener un presupuesto que dé crecimiento, que tenga equilibrio fiscal, que genere trabajo", subrayó.
Santilli también se refirió al malestar expresado por el PRO tras la designación de los nuevos auditores de la Auditoría General de la Nación, una decisión tomada durante la misma sesión legislativa y sin la participación de ese bloque ni de otros espacios aliados. Desde la bancada amarilla cuestionaron el acuerdo alcanzado entre La Libertad Avanza y Unión por la Patria y hablaron de una ruptura en la relación política.
Consultado sobre ese conflicto, el ministro reconoció la tensión, pero buscó bajar el tono. "La calentura del momento es válida", señaló, aunque aseguró que existe voluntad de recomponer el vínculo. "El trabajo que hace Cristian es muy importante y el trabajo que viene haciendo el PRO sosteniendo las reformas también lo es", indicó, en referencia al jefe del bloque macrista, Cristian Ritondo.
En relación con la agenda legislativa, Santilli destacó la reforma laboral como uno de los principales desafíos del Gobierno y remarcó la importancia del Senado como ámbito para profundizar el debate. "Tenemos dictamen, primero para empezar. Esto no pasaba nunca", afirmó, y agregó que se recibieron cerca de dos mil pedidos de audiencia para discutir el proyecto.
Finalmente, el ministro abordó la situación del empleo formal en el país y defendió la reforma laboral como una herramienta para reducir la informalidad. "Argentina tiene veintitrés millones de argentinos con posibilidad de trabajo. Seis millones lo tienen en el sector privado formal y tres millones en el sector público. ¿Qué pasa con el resto de los catorce millones? Entonces, ahí empieza la discusión", planteó, al señalar la necesidad de ampliar el empleo registrado y fortalecer la protección de los trabajadores.


 fm los angeles
fm los angeles

Comentarios
¡Sin comentarios aún!
Se el primero en comentar este artículo.
Deja tu comentario